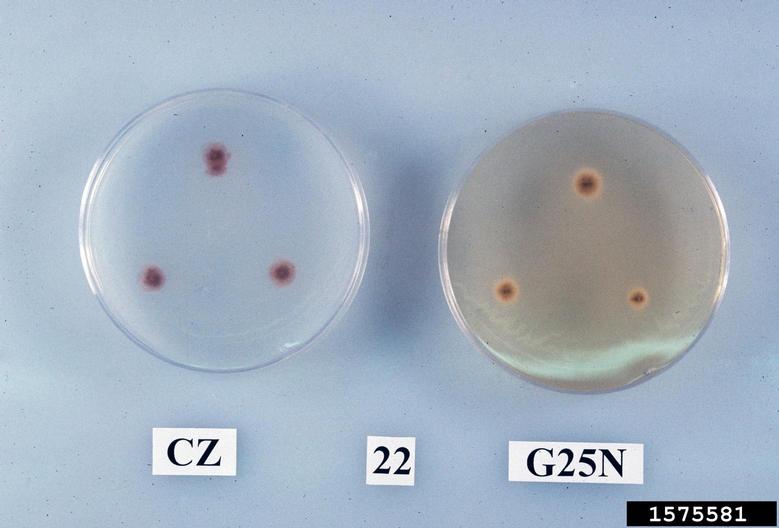

Image Number: 1575581
Photographer:
Descriptor:
Culture
Image view:
Identifying Feature
Description:
Reverse colony features of isolate 22 grown on Czapek Agar (left) and 25% Glycerol Nitrate Agar (right) for 5 days at 25C. August 1998
Image type:
Laboratory
You must attribute the work in the manner specified (but not in any way that suggests endorsement). You may not use this work for commercial purposes unless permission is granted by the photographer or copyright owner.
Image location:
, Raleigh
Node Affiliation:
Image taken:
Saturday, August 1, 1998
Image uploaded:
Friday, October 29, 2010
Image last updated:
Tuesday, January 14, 2014